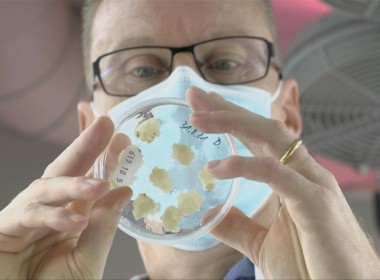

LONDON, United Kingdom (AFP) – UK aircraft engine maker Rolls-Royce on Tuesday launched plans to build small low-cost nuclear reactors to help cut the nation’s carbon emissions. The news comes as Britain pushes ahead with large-scale projects, including Hinkley Point C which will be the nation’s first new nuclear plant for a generation. Rolls-Royce said it had created a new Small Modular Reactor (SMR) division after clinching a cash injection of £405 million ($547 million, […]
Sci-Tech
France, US commemorate centenary of historic Marie Curie visit
by Lucie AUBOURG WASHINGTON, United States (AFP) — In 1921, the celebrated French scientist Marie Curie made a six-week trip to the United States, where she visited the White House and received from the hands of the president himself a very unusual gift: a gram of radium. At the time, the radioactive element was extremely hard to extract from minerals and could cost more than ten times as much as a diamond of the same […]
Astronaut becomes first Chinese woman to spacewalk
BEIJING, China (AFP) – Astronaut Wang Yaping became the first Chinese woman to walk in space, authorities said Monday, as her team completed a six-hour stint outside the Tiangong space station as part of its ongoing construction. Tiangong — meaning “heavenly palace” — is the latest achievement in China’s drive to become a major space power, after landing a rover on Mars and sending probes to the Moon. Its core module entered orbit earlier this […]
NASA to deflect asteroid in test of ‘planetary defense’
by Chris Lefkow WASHINGTON, United States (AFP) — In the 1998 Hollywood blockbuster “Armageddon,” Bruce Willis and Ben Affleck race to save the Earth from being pulverized by an asteroid. While the Earth faces no such immediate danger, NASA plans to crash a spacecraft traveling at a speed of 15,000 miles per hour (24,000 kph) into an asteroid next year in a test of “planetary defense.” The Double Asteroid Redirection Test (DART) is to determine […]
Finnish scientists create ‘sustainable’ lab-grown coffee
by Sam KINGSLEY HELSINKI, Finland (AFP) — Latte drinkers may in the future be sipping on java sourced from a petri dish rather than a plantation, say scientists behind a new technique to grow what they hope to be sustainable coffee in a lab. “It’s really coffee, because there is nothing else than coffee material in the product,” Heiko Rischer tells AFP, pointing to a dish of light brown powder. His team of researchers at […]
US targeting Feb. 2022 to launch new lunar program Artemis
WASHINGTON, United States (AFP) — NASA is aiming to launch its uncrewed lunar mission Artemis 1 in February next year, the space agency said Friday, the first step in America’s plan to return humans to the Moon. The agency had initially hoped to launch the test flight by the end of this year, with astronauts set to walk on the Moon by 2024. It achieved a major milestone Wednesday when it stacked the Orion […]
Canada hospitals use drones to carry lungs for transplant
by Geneviève NORMAND BROMONT, Canada (AFP) — In the dark of night, a drone takes off from a Toronto hospital rooftop, the hum of its rotors barely audible over the bustling sounds of the cars and pedestrians below in Canada’s largest metropolis. On its maiden flight, with a bird’s-eye view of the city’s glistening skyline as it glides over apartments, shops and office towers, the drone is carrying a precious cargo — human lungs for […]
Google cuts its commission on app subscriptions
SAN FRANCISCO, United States (AFP) — Google announced Thursday it will lower a fee in its app store as pressure mounts on tech giants to loosen their grip over their online marketplaces. The commission on subscriptions taken by Google Play will be lopped in half to 15 percent starting in January, vice president of product management Sameer Samat said in a blog post. Currently Google gets a 30 percent cut for the first year of […]
Trump announces plans to launch new social network ‘TRUTH Social’
by Sarah TITTERTON Agence France-Presse WASHINGTON, D.C., United States (AFP) – Former US president Donald Trump announced plans Wednesday to launch his own social network, in the latest push to reclaim his internet dominance after he was banned from Twitter and Facebook in the wake of the violent Capitol insurrection. “TRUTH Social” will be owned by Trump Media & Technology Group (TMTG), and is expected to begin its beta launch for “invited guests” next month. […]
New name for Facebook? Critics cry smoke and mirrors
SAN FRANCISCO, United States (AFP) — Facebook critics pounced Wednesday on a report the leading social network plans to rename itself, arguing it may be seeking to distract from recent scandals and controversy. The report from website The Verge, which Facebook refused to confirm, said the embattled company was aiming to show its ambition to be more than a social media site. But an activist group calling itself The Real Facebook Oversight Board, warned […]
China’s ‘space dream’: A Long March to the Moon and beyond
BEIJING, China (AFP) — The arrival of three astronauts at China’s new space station on Saturday marks a landmark step in its space ambitions, its longest crewed mission to date. The world’s second-largest economy has put billions into its military-run space programme, with hopes of having a permanently crewed space station by 2022 and eventually sending humans to the Moon. The country has come a long way in catching up with the United States […]
‘It was unbelievable’: Star Trek’s Shatner becomes real life astronaut
“Star Trek” actor William Shatner finally became a real space traveler on Blue Origin’s second crewed mission Wednesday, calling it the most profound experience of his life. “It was unbelievable,” said the 90-year-old Canadian, known to the sci-fi show’s legion of “Trekkies” as the daring Captain James T. Kirk, a role he first played more than half a century ago. He was joined on the 11-minute journey beyond Earth’s atmosphere and back again by […]